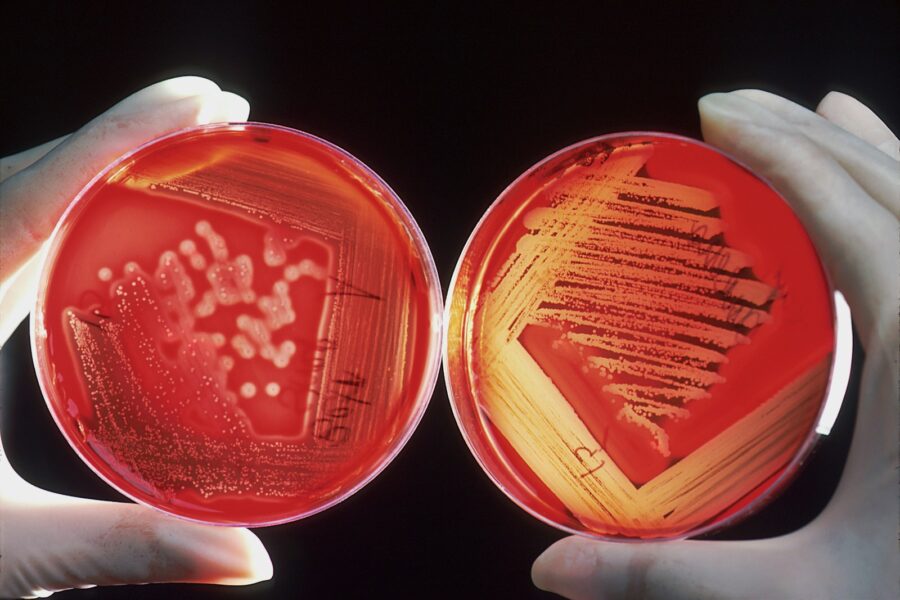
Kraujo vėžys dažnai nustatomas per vėlai: simptomai, kuriuos būtina žinoti kiekvienam

Kraujo vėžys dažnai nustatomas per vėlai: simptomai, kuriuos būtina žinoti kiekvienam
Daugelis žmonių neturi aiškaus supratimo, kokie gali būti kraujo vėžio simptomai, todėl ne visada žino, kada vertėtų kreiptis į gydytoją. Kraujo vėžys apima kelias ligas, įskaitant leukemiją, limfomą ir daugybinę mielomą. Leukemija – tai baltųjų kraujo kūnelių vėžys, besivystantis kaulų čiulpuose, limfoma pažeidžia limfinę sistemą, o daugybinė mieloma taip pat prasideda kaulų čiulpuose ir paveikia plazmines ląsteles.
Pastaraisiais metais šios ligos atvejų fiksuojama vis daugiau. Teigiama, kad kraujo vėžys kasmet nusineša daugiau gyvybių nei krūties ar prostatos vėžys, tačiau visuomenėje vis dar trūksta žinių apie problemos mastą. Pasak onkologų, kasmet visame pasaulyje diagnozuojami milijonai kraujo vėžio atvejų, tačiau dėl vėlyvo nustatymo prognozės neretai išlieka prastos.
Skaičiuojama, kad apie 30 proc. kraujo vėžio atvejų nustatoma tik tuomet, kai žmogus skubiai hospitalizuojamas, o tai smarkiai sumažina išgyvenimo tikimybę. Jei liga aptinkama anksti, kai pacientą įvertina šeimos gydytojas, penkerių metų išgyvenamumas gali siekti 77 proc., o nustačius vėlai – apie 40 proc. Tai rodo, kad informuotumas apie kraujo vėžį išlieka nepakankamas, o dalis žmonių tiesiog nežino, kada būtina ieškoti pagalbos.
Ankstyvieji kraujo vėžio požymiai dažnai būna neryškūs ir nespecifiniai, todėl diagnozę nustatyti sudėtinga. Dažniausiai minimi simptomai: nepaaiškinamas svorio kritimas, lėtinis nuovargis, dažnas mėlynių atsiradimas, patinimai ar padidėję limfmazgiai, gausus prakaitavimas, pakilusi temperatūra, dusulys, nuolatinės arba pasikartojančios infekcijos, odos blyškumas, bėrimai ir niežulys.
Negydomas kraujo vėžys gali progresuoti ir sukelti rimtų komplikacijų. Netinkamai funkcionuojančios kraujo ląstelės užpildo kaulų čiulpus ir limfagysles, todėl gali atsirasti kaulų skausmas, ryškėti mažakraujystė, stiprėti dusulys, pasireikšti krūtinės skausmas, silpnėti imuninė sistema. Dėl to didėja infekcijų, plaučių uždegimo ir sepsio rizika. Sunkiais atvejais liga gali paveikti ir smegenis – tuomet galimi galvos skausmai bei traukuliai.
Sekite mūsų naujienas patogiau
- Pridėkite mus kaip mėgstamiausią šaltinį „Google Discover“, kad nepraleistumėte svarbiausių naujienų.
- Taip pat galite mus nustatyti kaip pageidaujamą šaltinį „Google“ paieškoje.










